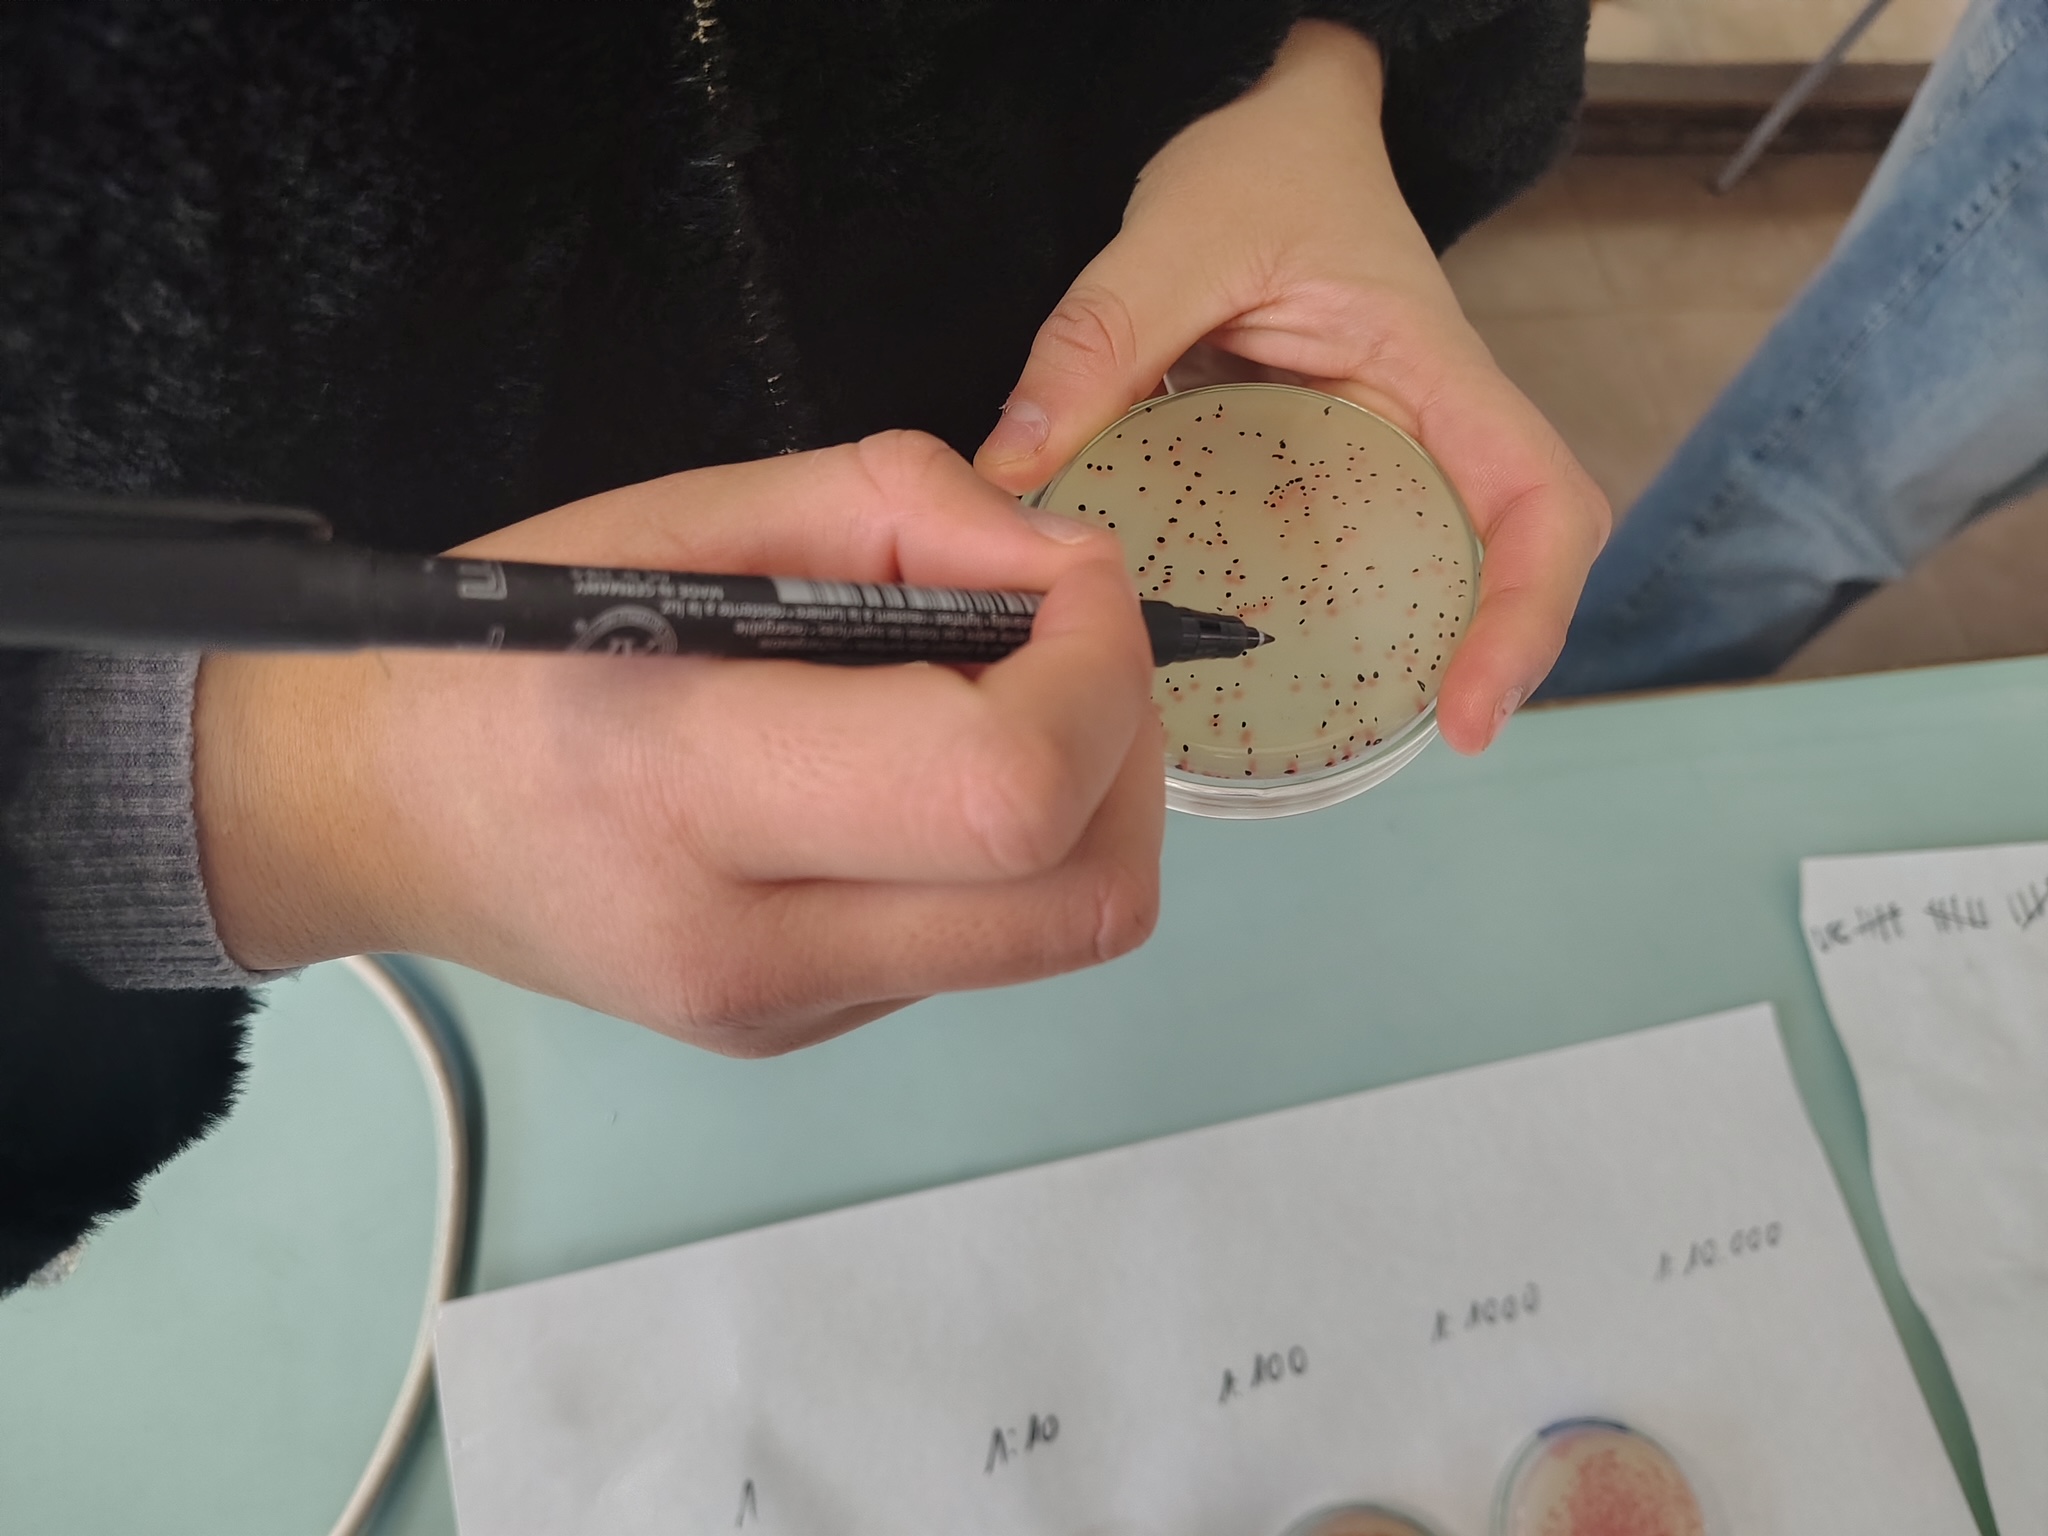

Llista puntuació provisional ESO curs 2026-2027 15.04.2026
Llista barem reclamacions resoltes ESO curs 2026-2027 23.04.2026
Llista barem ordenada ESO curs 2026-2027 29.04.2026
Llista barem provisional Batxillerat curs 2026-2027 14.05.2026
Llista barem reclamacions resoltes Batxillerat curs 2026-2027 26.05.2026
Llista barem ordenada Batxillerat curs 2026-2027 29.05.2026
El primer trimestre, la biblioteca recomana
El segon trimestre, la biblioteca recomana
El tercer trimestre, la biblioteca recomana
Instruccions per sol·licitar els llibres de socialització de l’AFA

Segueix-nos!